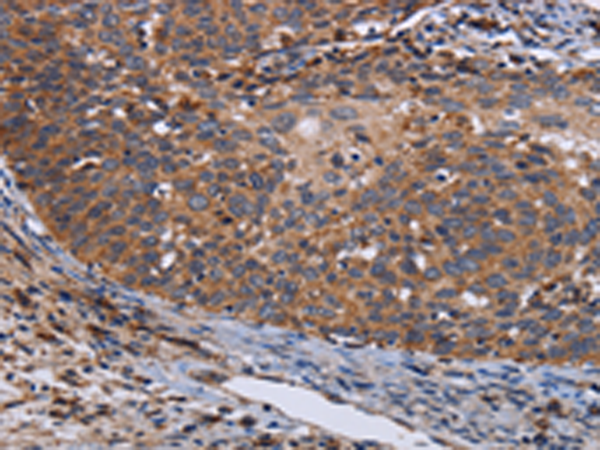
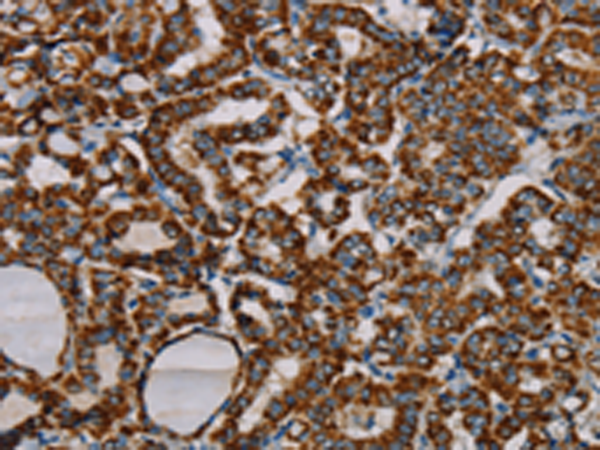

-
分类: 科研抗体货号: P08508别名: GIF; GIFB; GRIF; ZnMT3应用: IHC反应种属: Human, Mouse, Rat
-
分类: 科研抗体货号: P08487别名:应用: WB,IHC反应种属: Human, Mouse, Rat
-
分类: 科研抗体货号: P08524别名: L39mt; MRPL5; RPML5; MRP-L5; PRED22; PRED66; MSTP003; C21orf92应用: WB,IHC反应种属: Human, Mouse
-
分类: 科研抗体货号: P08507别名: PPHA应用: WB反应种属: Human, Rat
-
分类: 科研抗体货号: P08486别名:应用: WB,IHC反应种属: Human, Mouse, Rat
-
分类: 科研抗体货号: P08523别名: p15; MAAT1应用: WB,IHC反应种属: Human, Mouse
-
分类: 科研抗体货号: P08506别名: SPATA38应用: IHC反应种属: Human
-
分类: 科研抗体货号: P08485别名: LIB应用: IHC反应种属: Human, Mouse, Rat
-
分类: 科研抗体货号: P08522别名: 5c5-2; L12mt; MRPL7; RPML12; MRPL7/L12; MRP-L31/34应用: WB,IHC反应种属: Human, Mouse
-
分类: 科研抗体货号: P08504别名: MDHA; MOR2; MDH-s; HEL-S-32; MGC:1375应用: WB反应种属: Human, Mouse, Rat

鄂公网安备42018502007531号
鄂公网安备42018502007531号

